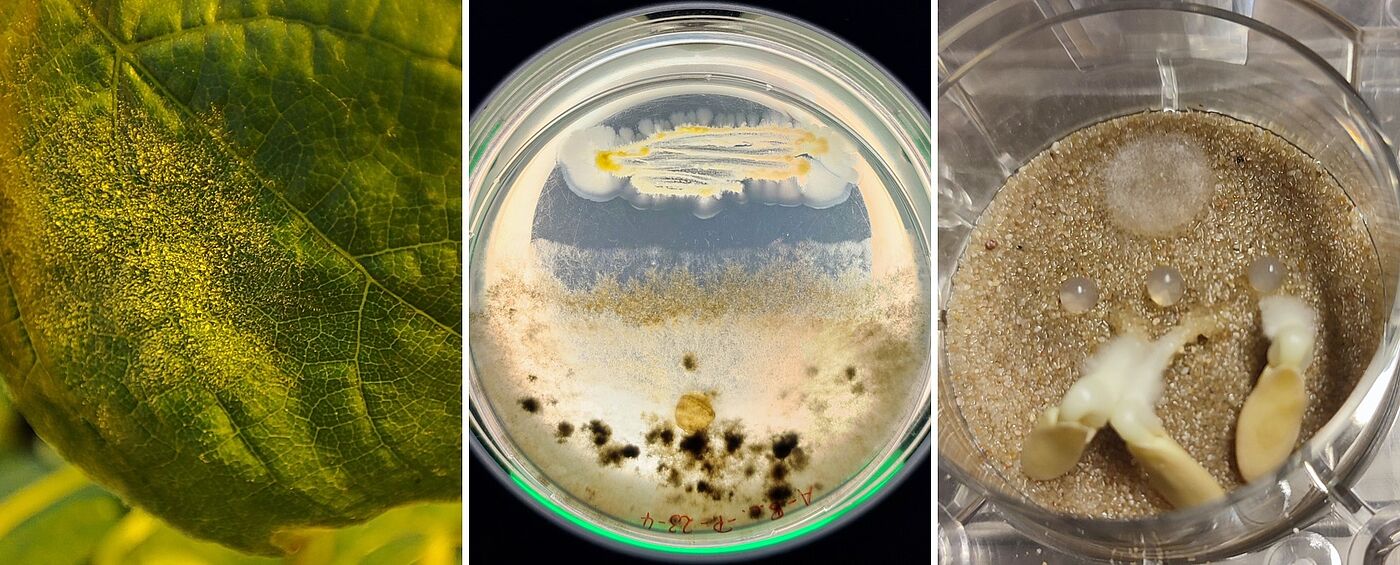

Der persönliche Austausch mit Ihnen ist für uns ein echtes Highlight im Januar 2024. In Halle 3, Stand D64 informieren wir Sie gerne über aktuelle Forschungs- und Praxisprojekte und freuen uns insbesondere, Sie zu unserem Studienangebot beraten zu dürfen:
Detaillierte Informationen zur Messe IPM 2024 finden Sie hier
Aus unserer Forschung:
Als Exponate werden Wurzelschaukästen mit verschiedenen Salatsorten ausgestellt, sowie Glaskaraffen mit Basilikum und Buntnesseln.
In Halle 4 B13.3 (Innovationscenter) stellen wir unsere ForschungsprojekteCityDigiSpace, GeoSenSys, dieWinUM-App sowie Antagonisten als Protagonisten für einen zukunftsfähigen Pflanzenschutz vor.
Vorträge und Präsentationen:
Vortrag am Dienstag, 23.01.2024 – 15:00 Uhr
Referenten: Luisa Pizzini, B.Sc. und David Weinrich, M.A.
Nachhaltigkeit in Privatgärten mittels App messen und verbessern
Vortrag am Mittwoch, 24.01.2024, 11:00 Uhr
Referentin: Samantha Rubo, M.Sc.
Integration von Künstlicher Intelligenz für die Bewässerungssteuerung im Freilandgemüsebau
Vortrag am Donnerstag, 25.01.2024, 11:30 Uhr
Referent: Benjamin Spehle, M.Sc.
WinUM 2.0 - Die Folgen des Klimawandels im virtuellen Weinberg vermitteln

Das Projekt CititDigiSpace dient der Erfassung und Verbesserung der Nachhaltigkeit in Privatgärten. Dabei stehen neben der ökologischen Nachhaltigkeit auch die soziale und ökonomische Nachhaltigkeit im Fokus. Zentraler Teil des Forschungsprojektes ist die eigens dafür entwickelte App „GardenUp“, die kostenlos für iPhones verfügbar ist.
GardenUp erfasst die verschiedenen Nachhaltigkeitssparten über einen Fragebogen und gibt automatisiert Maßnahmen aus, mit denen der Garten des teilnehmenden Haushaltes nachhaltiger gestaltet werden kann. Feedback zur Nachhaltigkeit des Gartens wird den Teilnehmer:innen in Form von Nachhaltigkeitsleveln angezeigt, in denen sie durch das Umsetzen von Maßnahmen auch aufsteigen können. Das Nachhaltiskeitslevel sowie ein Vergleich mit anderen Nutzer:innen der App sollen zur Nachhaltigkeitsverbesserung anspornen.
Für die kommende Gartensaison wird die App mit neuen Features ausgestattet. Hierzu zählt Input zur klima- und standortgerechten Bepflanzung mit Stauden und Bäumen, unter Nutzung der im iPhone integrierten LiDAR-Technologie, sowie die Kommunikation oder Vernetzung von Gärtner:innen innerhalb der App.

Institut für Gemüsebau entwickelt georeferenziertes, sensorgestütztes Tool zum gekoppelten Management von Stickstoffdüngung und Bewässerung
Das Entscheidungshilfesystem GeoSenSys ist als GIS-basierte Webanwendung konzipiert, um die Anwender durch Empfehlungen für standortspezifische Bewässerung und Stickstoff(N)-Düngung zu unterstützen. Ein Fokus des Projekts ist die Entwicklung eines neuronalen Netzwerks für Bewässerung auf Basis der spektralen Reflexion des Modellkultur Spinat sowie gemessener Boden-, Pflanzen- und Umweltparameter. Der Bewässerungsbedarf wird abgeleitet, indem die Wasserbilanz der Kultur mit der Geisenheimer Bewässerungssteuerung, Bodenfeuchtemessungen und spektralen Vegetationsindizes kombiniert wird. Die wissenschaftliche Verifizierung des modellierten Wasserbedarfs erfolgt durch die Messung der aktuellen Evapotranspiration mittels Analysen der Eddy-Kovarianz. Um die Verknüpfung von Bewässerungs- und N-Düngungsentscheidungen zu ermöglichen, wird ein Mineralisierungsmodell entwickelt und mit dem Bewässerungsmodell verknüpft. Dies ermöglicht eine einfache Entscheidungsfindung für das Anbaumanagement im Gemüsebau. Durch die präzise Schätzung des Bewässerungs- und N-Düngungsbedarfs trägt dieses Projekt zur ressourceneffizienten und nachhaltigen Gemüseproduktion bei.

Das Projekt WinUM 2.0 will Lehr- und Lernmaterialien entwickeln und bereitstellen, die an Weinberg und Weinrebe (Vitis vinifera L.) die Folgen des Klimawandels im Schulunterricht sichtbar machen können. Dabei wollen wir die aktuellen Forschungsergebnisse
aus dem VineyardFACE und dem in diesem Kontext entwickelten Modell Virtueller Riesling (ViRi, Schmidt et al. 2019) nutzen.
Ein Schwerpunkt des Projektes ist es, schultaugliche Simulationen zu entwickeln. Hier zeigen wir auf, wie über eine neue grafische Benutzeroberfläche (GUI) ein Wissenstransfer von der Forschung in die Schule realisiert werden kann.
Forschungsprojekte aus dem Institut für Phytomedizin der Hochschule Geisenheim, vorgestellt durch Kittima Yubonphan und Linda Muskat
Die Gesundheit unserer Kulturpflanzen wird durch eine Vielzahl an Krankheitserregern bedroht, weshalb zur kommerziellen Erzeugung von Obst und Gemüse Pflanzenschutz betrieben werden muss. Jedoch werden die negativen Auswirkungen des jahrzehntelang hohen Einsatzes an chemisch-synthetischen Pflanzenschutzmitteln immer deutlicher. Dadurch steigt die Nachfrage nach alternativen Wirkstoffen und Präparaten, um einen weiterhin wirksamen, aber gleichzeitig umweltschonenden Pflanzenschutz betreiben zu können.
Natürliche mikrobielle Gegenspieler der Schaderreger, sogenannte Antagonisten, verfügen über großes Potential als Pflanzenschutzmittel eingesetzt zu werden. Diese Antagonisten produzieren zum Beispiel Abwehrstoffe, um sich gegen andere Mikroorganismen durchzusetzen und sich so Lebensraum und Nahrung zu verschaffen. Und genau diese Eigenschaft kann man sich zu Nutze machen, indem man einen Antagonisten gezielt auf die Kulturpflanzen aufbringt, damit sich dort kein Schaderreger mehr etablieren kann. Wo man solch einen lebenden Antagonisten finden kann und wie man ihn in ein Pflanzenschutzmittel verwandelt, erfahrt ihr am Stand der Phytomedizin.







